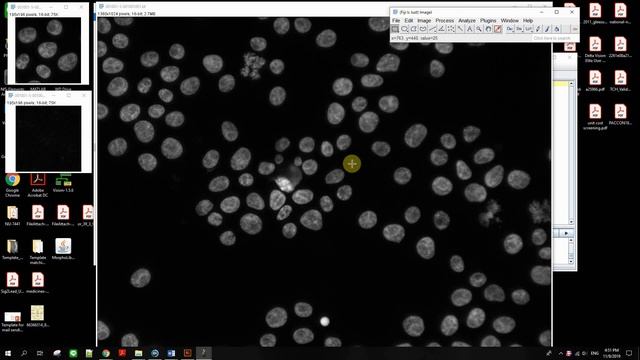
Template matching with ImageJ смотреть онлайн

Автор / Канал: Питониум Страница 7

Hooke vs Newton Laws, Manim, Python, MATLAB, Theoretical Physics, Vector Fields. RK4

TD2 - Basics of Python and Data Analysis (String Slicing)
Template matching with ImageJ

Django : NOT NULL constraint failed error when populating foreign key field

How to Install Django 2.1 || in Hindi ||

How to Create Alert Message Using Django ? | Tamil.

AMICABLE NUMBERS AT A GLANCE BY RAVISIR

Doubts Class-63: CUET, JAM, GATE & NET 2024 | Statistics & Mathematics | Mathstats@9958472126

Session 2 Recreate Authenticatoin for Deribit or Use Deribit Package

Threads Concept Map Explanation

What is TLE? | How To Avoid Time Limit Exceeded Error | Interview Preparation Course

Lean Logger | Discord Malware

How to Create a Library Management System in Excel - Full Tutorial

How to Make a Cheat Sheet Document

Use strcpy( ) Function in C | String in C Language | by Rahul Chaudhary

sky crops - Tree Detection using TensorFlow Object Detection API ▮ sky gate

El nuevo le sabe al python (versión LibreOffice)

Hola Mundo en Django - El Workflow de Django Parte 1/2 - Python Web Development

รู้จักข้อมูล MNIST ลายมือเขียนตัวเลข 0-9 (handwritten digits)

Chat Client-Server Application

CONFERENCIA. JULIÁN SAGREDO. 10o CONGRESO METROPOLITANO DE MODELADO Y SIMULACIÓN NUMÉRICA.

#20. Serve & Design Login Page || E-commerce website in django || Python World || Django

Swans SRX-M Mirror Racing Goggles - www.fit4swimming.co.uk

Побудова діаграм і графіків
За каждым успешным каналом стоит личность, идея и сотни часов кропотливого труда. Если вы здесь, значит, автор «Питониум» уже сумел зацепить ваше внимание своим уникальным стилем или подачей. А мы на RUVIDEO позаботились о том, чтобы вы могли изучить весь архив его работ в максимально комфортных условиях — без лишней суеты и преград.
Почему за работами канала «Питониум» так интересно наблюдать? Всё просто: это честный контент, который находит отклик в сердцах зрителей. На нашем ресурсе вы можете смотреть онлайн все видео любимого автора бесплатно и в хорошем качестве. Нам важно, чтобы вы видели каждую деталь и слышали каждый нюанс, поэтому мы используем только стабильные плееры из открытых источников Rutube.
Следите за новинками канала, пересматривайте старые шедевры и открывайте для себя новые грани творчества «Питониум». Мы постоянно обновляем ленту, чтобы у вас под рукой всегда были самые свежие выпуски. Никаких сложных регистраций — только вы и творчество, которое вдохновляет. Приятного вам путешествия по миру авторского контента на RUVIDEO!
Видео взято из открытых источников Rutube. Если вы правообладатель, обратитесь к первоисточнику.